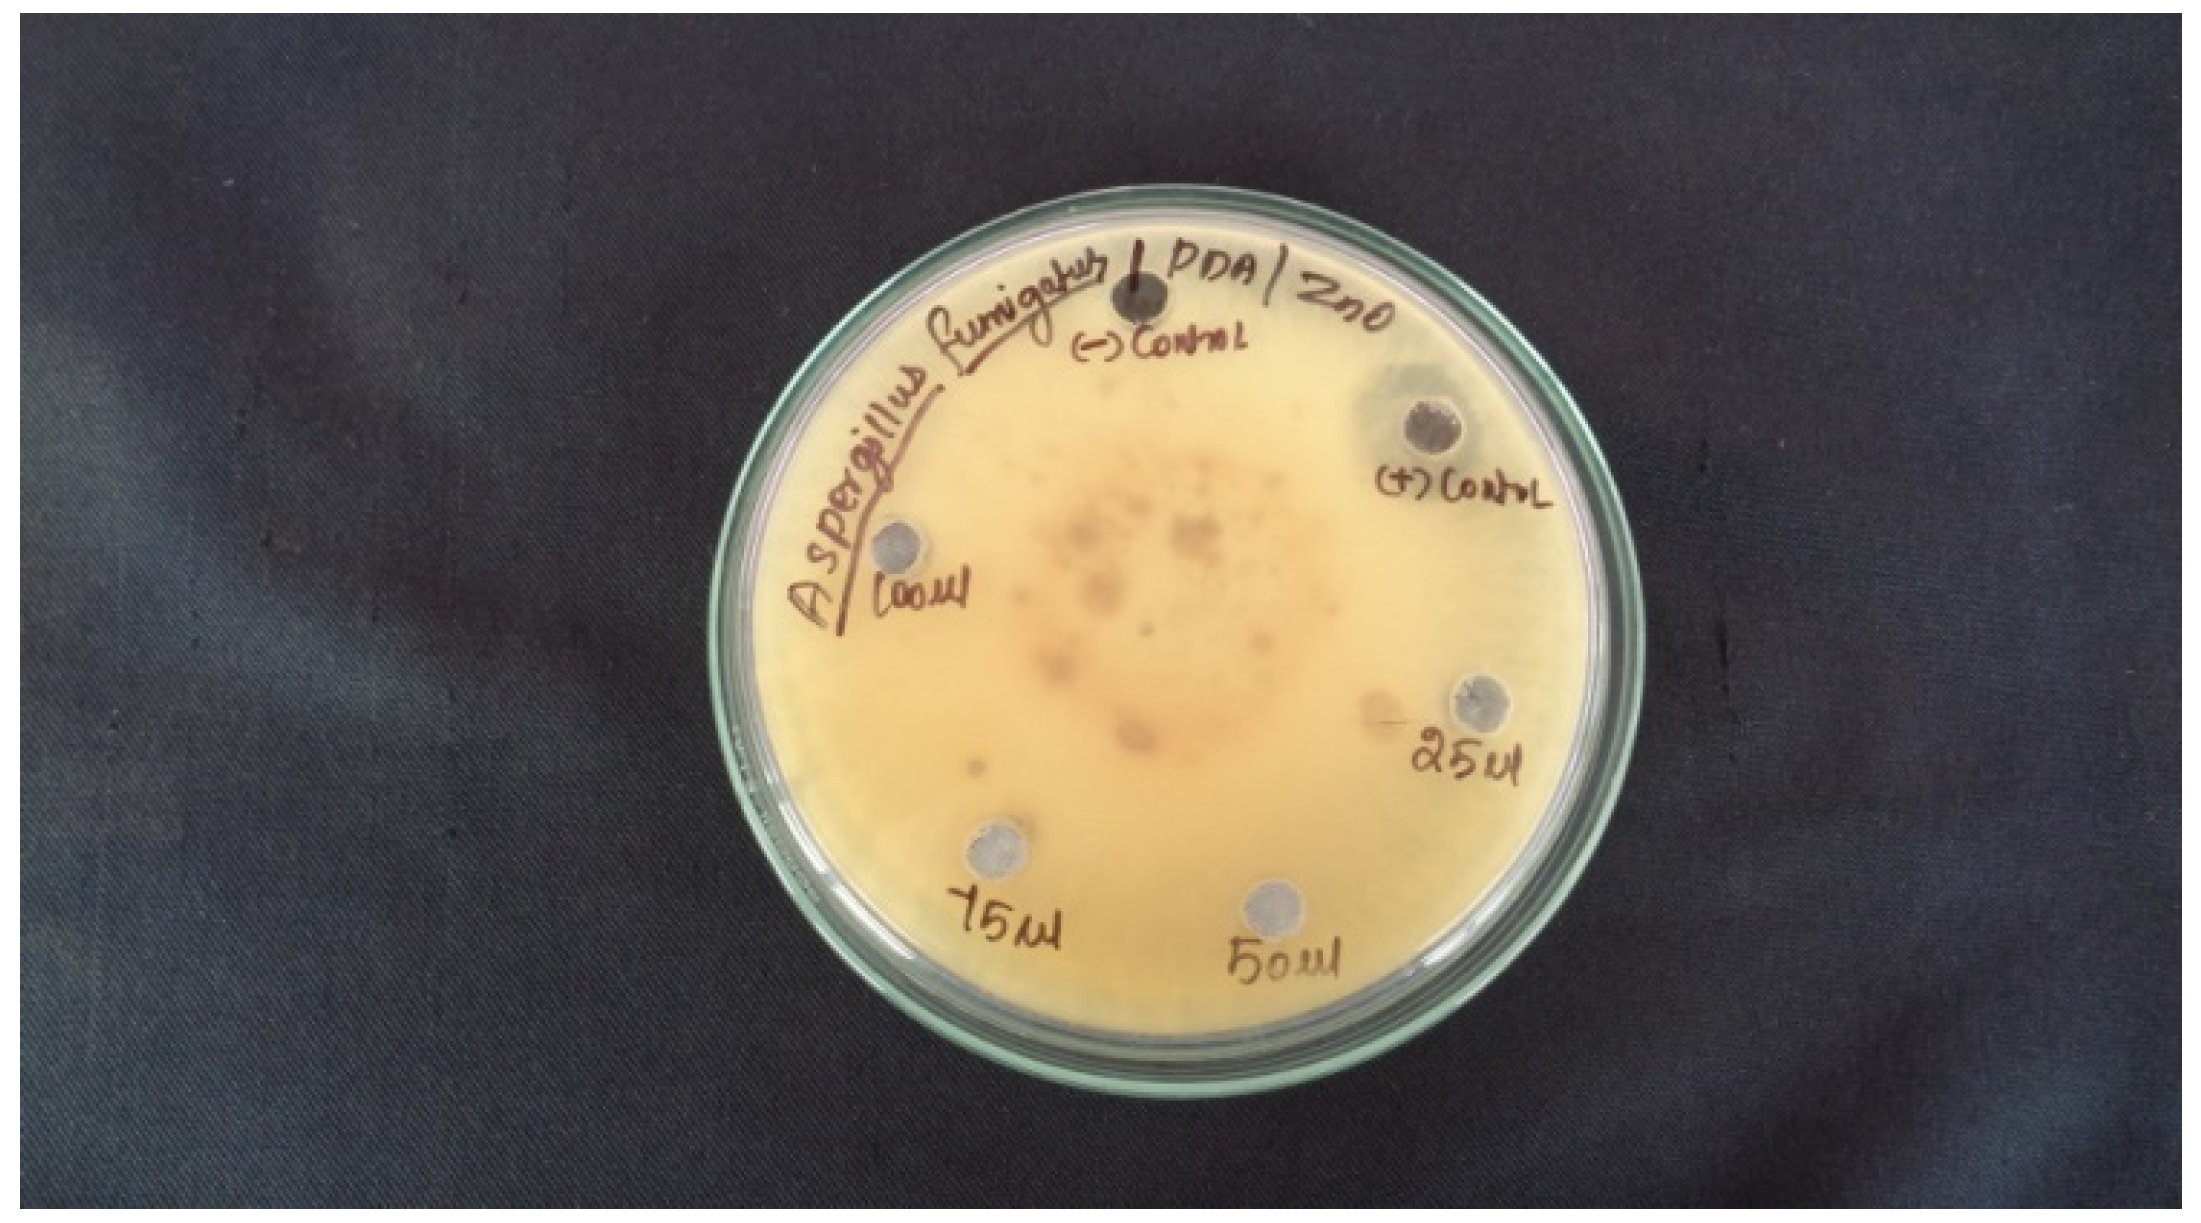
Molecules 27 01545 g007 550

Nanotechnology, Green Synthesis and Biological Activity Application of Zinc Oxide Nanoparticles Incorporated Argemone Mxicana Leaf Extract
Abstract
:1. Introduction
2. Results and Discussion
2.1. X-ray Diffraction Analysis
- k = Scherrer’s constant (0.9)
- λ = Wavelength of X-ray (1.54 × 10−10 m)
- β = Full Width Half Maximum
- θ = Bragg’s angle
2.2. FTIR Analysis
2.3. Scanning Electron Microscopic Analysis (SEM)
2.4. Energy-Dispersive X-ray Spectroscopy
2.5. Ultraviolet—Visible (UV-Vis) Spectroscopy
2.6. Antibacterial Activity
2.7. Antifungal Activity
2.8. Antioxidant Activity
3. Materials and Methods
3.1. Preparation of Leaf Extract
3.2. Biosynthesis of Zinc Oxide Nanoparticle
3.3. Antibacterial Activity Assay
3.4. Antifungal Activity Assay
3.5. Antioxidant Activity
4. Conclusions
Author Contributions
Funding
Institutional Review Board Statement
Informed Consent Statement
Data Availability Statement
Acknowledgments
Conflicts of Interest
Sample Availability
References
- Bayda, S.; Adeel, M.; Tuccinardi, T.; Cordani, M.; Rizzolio, F. The History of Nanoscience and Nanotechnology: From Chemical–Physical Applications to Nanomedicine. Molecules 2020, 25, 112. [Google Scholar] [CrossRef] [PubMed] [Green Version]
- Gonçalves, R.; Toledo, R.; Joshi, N.; Berengue, O. Green Synthesis and Applications of ZnO and TiO2 Nanostructures. Molecules 2021, 26, 2236. [Google Scholar] [CrossRef] [PubMed]
- Patra, J.K.; Das, G.; Fraceto, L.F.; Campos, E.V.; Rodriguez-Torres, M.D.; Acosta-Torres, L.S.; Diaz-Torres, L.A.; Grillo, R.; Swamy, M.K.; Sharma, S.; et al. Nano based drug delivery systems: Recent developments and future prospects. J. Nanobiotechnol. 2018, 16, 71. [Google Scholar] [CrossRef] [PubMed] [Green Version]
- Schultz, S.; Smith, D.R.; Mock, J.J.; Schultz, D.A. Single-target molecule detection with nonbleaching multicolor optical im-munolabels. Proc. Natl. Acad. Sci. USA 2000, 97, 996–1001. [Google Scholar] [CrossRef] [Green Version]
- Rai, M.; Yadav, A.; Gade, A. Silver nanoparticles as a new generation of antimicrobials. Biotechnol. Adv. 2009, 27, 76–83. [Google Scholar] [CrossRef]
- Elechiguerra, J.L.; Burt, J.L.; Morones, J.R.; Camacho-Bragado, A.; Gao, X.; Lara, H.H.; Yacaman, M.J. Interaction of Silver Na-noparticles with HIV-1. J. Nanobiotechnol. 2005, 3, 6. [Google Scholar] [CrossRef] [PubMed] [Green Version]
- Kritsanaviparkporn, E.; Baena-Moreno, F.; Reina, T. Catalytic Converters for Vehicle Exhaust: Fundamental Aspects and Technology Overview for Newcomers to the Field. Chemistry 2021, 3, 44. [Google Scholar] [CrossRef]
- Gittins, D.I.; Bethell, D.; Nichols, R.J.; Schiffrin, D.J. Diode-like electron transfer across nanostructured films containing a re-dox ligand. J. Mater. Chem. 2000, 10, 79–83. [Google Scholar] [CrossRef]
- Kinnear, C.; Moore, T.L.; Rodriguez-Lorenzo, L.; Rothen-Rutishauser, B.; Petri-Fink, A. Form Follows Function: Nano-particle Shape and Its Implications for Nanomedicine. Chem. Rev. 2017, 117, 11476–11521. [Google Scholar] [CrossRef]
- Renuka, R.; Devi, K.R.; Sivakami, M.; Thilagavathi, T.; Uthrakumar, R.; Kaviyarasu, K. Biosynthesis of silver na-noparticles using phyllanthus emblica fruit extract for antimicrobial application. Biocatal. Agric. Biotechnol. 2020, 24, 101567. [Google Scholar] [CrossRef]
- Kosikowska, U.; Wujec, M.; Trotsko, N.; Płonka, W.; Paneth, P.; Paneth, A. Antibacterial Activity of Fluorobenzoyl thiosemicarbazides and Their Cyclic Analogues with 1,2,4-Triazole Scaffold. Molecules 2021, 26, 170. [Google Scholar] [CrossRef]
- Henglein, A. Reduction of Ag(CN)2- on Silver and Platinum Colloidal Nanoparticles. Langmuir 2001, 17, 2329–2333. [Google Scholar] [CrossRef]
- Rodríguez-Sánchez, L.; Blanco, A.M.C.; López-Quintela, M.A. Electrochemical Synthesis of Silver Nanoparticles. J. Phys. Chem. B 2000, 104, 9683–9688. [Google Scholar] [CrossRef]
- Zhu, J.J.; Liu, S.W.; Palchik, O.; Koltypin, Y.; Gedanken, A. Shape-Controlled Synthesis of Silver Nanoparticles by Pulse Sono-electrochemical Methods. Langmuir 2000, 16, 6396. [Google Scholar] [CrossRef]
- Pastoriza-Santos, I.; Liz-Marzan, L.M. Formation of PVP-Protected Metal Nanoparticles in DMF. Langmuir 2002, 18, 2888. [Google Scholar] [CrossRef]
- Begum, N.; Mondal, S.; Basu, S.; Laskar, R.A.; Mandal, D. Biogenic synthesis of Au and Ag nanoparticles using aqueous solutions of Black Tea leaf extracts. Colloids Surfaces B Biointerfaces 2009, 71, 113–118. [Google Scholar] [CrossRef]
- Bar, H.; Bhui, D.K.; Sahoo, G.P.; Sarkar, P.; De, S.P.; Misra, A. Green synthesis of silver nanoparticles using latex of Jatropha curcas. Colloids Surfaces A Physicochem. Eng. Asp. 2009, 339, 134–139. [Google Scholar] [CrossRef]
- Song, J.Y.; Kim, B.S. Rapid biological synthesis of silver nanoparticles using plant leaf extracts. Bioprocess Biosyst. Eng. 2009, 32, 79–84. [Google Scholar] [CrossRef]
- Jain, D.; Daima, H.K.; Kachhwaha, S.; Kothari, S.L. Digest, Synthesis of Plant-Mediated Silver Nanoparticles using Papaya Fruit Extract and Evaluation of their Anti-Microbial Activities. J. Nanomater. Biostruct. 2009, 4, 557–563. [Google Scholar]
- Saifuddin, N.; Wong, C.W.; Yasumira, A.A.N. Rapid Biosynthesis of Silver Nanoparticles Using Culture Supernatant of Bacteria with Microwave Irradiation. J. Chem. 2009, 6, 61–70. [Google Scholar] [CrossRef]
- Bindhu, M.R.; Ancy, K.; Umadevi, M.; AliEsmail, G.; AbdullahAl-Dhabi, N.; ValanArasu, M. Synthesis and characterization of zinc oxide nanostructures and its assessment on enhanced bacterial inhibition and photocatalytic degradation. J. Photochem. Photobiol. B Biol. 2020, 210, 111965. [Google Scholar] [CrossRef]
- Willner, I.; Basnar, B.; Willner, B. Nanoparticle-enzyme hybrid systems for nanobiotechnology. FEBS J. 2006, 274, 302–309. [Google Scholar] [CrossRef] [Green Version]
- Toy, R.; Peiris, P.M.; Ghaghada, K.B.; Karathanasis, E. Shaping cancer nanomedicine: The effect of particle shape on the in vivo journey of nanoparticles. Nanomedicine 2014, 9, 121–134. [Google Scholar] [CrossRef] [Green Version]
- Weissig, V.; Pettinger, T.K.; Murdock, N. Nanopharmaceuticals (part 1): Products on the market. Int. J. Nanomed. 2014, 9, 4357–4373. [Google Scholar] [CrossRef] [Green Version]
- Brahmachari, G.; Gorai, D.; Roy, R. Argemone mexicana: Chemical and pharmacological aspects. Rev. Bras. Farm. 2013, 23, 559–575. [Google Scholar] [CrossRef] [Green Version]
- Zhang, Y.; Nayak, T.; Hong, H.; Cai, W. Biomedical Applications of Zinc Oxide Nanomaterials. Curr. Mol. Med. 2013, 13, 1633–1645. [Google Scholar] [CrossRef] [Green Version]
- Dressler, S.; Schmidt, M.; Ziizika, G. “Argemone Mexicana”. African plants—A Photo Guide; Schungs Institute Senckenberg: Frankfurt, Germany, 2014. [Google Scholar]
- Kumar, D.S.; Sivaranjani, S.; Umamaheswari, M.; Ravikumar, B. Green synthesis of ZnO nanoparticles using Tra-chyspermum ammi seed extract for antibacterial investigation. Pharma Chem. 2016, 8, 173–180. Available online: http://derpharmachemica.com/archive.html (accessed on 29 December 2021).
- Hudlikar, M.; Joglekar, S.; Dhaygude, M.; Kodam, K. Latex-mediated synthesis of ZnS nanoparticles: Green synthesis approach. J. Nanopart. Res. 2012, 14, 0865. [Google Scholar] [CrossRef]
- AL-Asady, Z.M.; AL-Hamdani, A.H.; Hussein, M.A. Study the optical and morphology properties of zinc oxide nanoparticles. AIP Conf. Proc. 2020, 2213, 020007. [Google Scholar]
- Bassyouni, F.; El Hefnawi, M.; El Rashed, A.; Rehim, M.A. Molecular Modeling and Biological Activities of New Potent Antimicrobial, Anti-Inflammatory and Anti-Nociceptive of 5-Nitro Indoline-2-One Derivatives. Drug Des. Open Access 2017, 6, 1–6. [Google Scholar] [CrossRef]
- Bassyouni, F.; Tarek, M.; Salama, A.; Ibrahim, B.; el Dine, S.S.; Yassin, N.; Has-sanein, A.; Moharam, M.; Abdel-Rehim, M. Promising Antidiabetic and Antimicrobial Agents Based on Fused Pyrimi-dine Derivatives: Molecular Modeling and Biological Evaluation with Histopathological Effect. Molecules 2021, 26, 2370. [Google Scholar] [CrossRef] [PubMed]
- García-López, J.I.; Zavala-García, F.; Olivares-Sáenz, E.; Lira-Saldívar, R.H.; Diaz Barriga-Castro, E.; Ruiz-Torres, N.A.; Ramos-Cortez, E.; Vázquez-Alvarado, R.; Niño-Medina, G. Zinc Oxide Nanoparticles Boosts Phenolic Compounds and Antioxidant Activity of Capsicum annuum L. during Germination. Agronomy 2018, 8, 215. [Google Scholar] [CrossRef] [Green Version]

| S.NO | 2 θ Degree | d A° | FWHM (deg) | Hkl | Crystalline Size (nm) | Average Crystal Size (nm) |
|---|---|---|---|---|---|---|
| 1. | 31.737 | 2.820 | 0.56300 | 100 | 1.47129 | 1.461449 |
| 2. | 34.379 | 2.608 | 0.54300 | 002 | 1.532493 | |
| 3. | 36.215 | 2.480 | 0.60570 | 101 | 1.380564 |
| Peak Value | Chemical Bonding |
|---|---|
| 871 cm−1 | C=C bending |
| 3196 cm−1 | O=H Stretching |
| 1626 cm−1 | C=C Stretching |
| 1650 cm−1 | C=N Stretching |
| 1102 cm−1 | C-O Stretching |
| Sample | At of (Zn) | At of (O) |
|---|---|---|
| ZNp | 32.05 | 34.58 |
| Sample No | Sample Marking | Sample Concentration | Test Organisms and Zone of Inhibition in (mm) | |
|---|---|---|---|---|
| Staphylococcus aureus | E. coli | |||
| 2 | Control | MHA | NA | NA |
| 3 | Leaf Extract | 75 µL | NA | 8 mm |
| 4 | 100 µL | 7 mm | 11 mm | |
| Sample No | Sample Marking | Sample Concentration | Zone of Inhibition in (mm) |
|---|---|---|---|
| Aspergillus fumiga | |||
| 2 | Control | PDA | NA |
| 3 | ZnO AML | 25 µL | 5 mm |
| 4 | 75 µL | NA | |
| 5 | Leaf Extract | 50 µL | NA |
| 6 | 100 µL | 13 mm |
| Sample No | Extract Concentration (μg/mL) | DPPH Antioxidant Activity | ||
|---|---|---|---|---|
| OD Value at 517 nm (in Triplicates) | ||||
| 1 | 500 μg/mL | 1.613 | 1.244 | 1.507 |
| 2 | 250 μg/mL | 0.108 | 0.120 | 0.122 |
| 3 | 100 μg/mL | 0.152 | 0.153 | 0.198 |
| 4 | 50 μg/mL | 0.211 | 0.236 | 0.247 |
| 5 | 10 μg/mL | 0.283 | 0.253 | 0.273 |
| 6 | Control | 1.189 | 1.148 | 1.116 |
| Sample No | Standard | Concentration (g/mL) |
Antioxidant Activity % of Inhibition |
|---|---|---|---|
| DPPH (510 nm) | |||
| 1 | Ascorbic acid used as a standard (OD value) | 500 μg/mL | 91.97 |
| 2 | 250 μg/mL | 88.46 | |
| 3 | 100 μg/mL | 84.08 | |
| 4 | 50 μg/mL | 81.44 | |
| 5 | 10 μg/mL | 20.83 |
| Day | Materials and Methods | Process |
|---|---|---|
| I | 3.8 g of Zinc acetate dihydrate+ 50 mL of distilled water | Stirred for 30 min. |
| 10 g leaves of Argemone maxicana+50 mL of distilled adding 60 mL of leaf extract (drop wise) | Stirred for 20 min + Filtering extract with whatmann filter paper. | |
| Formation of Zinc nanoparticles (deep emerald green color) | 1hour of stirring (PH = 12) and then kept in room temp. | |
| II | Deep emerald green precipitation was formed | Per day for Two times water changed. |
| III | Deep emerald green precipitation was formed | Per day for Two times water changed. |
| IV | Dried in hot air oven at 100 °C for Five hour | Sample transferred to silica crucible cup. |
| V | Heated in muffle furnace at 400 °C for 2 h. White precipitation was formed finally. | Grained in mortar ZnO Nano powder. |
Publisher’s Note: MDPI stays neutral with regard to jurisdictional claims in published maps and institutional affiliations. |
© 2022 by the authors. Licensee MDPI, Basel, Switzerland. This article is an open access article distributed under the terms and conditions of the Creative Commons Attribution (CC BY) license (https://creativecommons.org/licenses/by/4.0/).
Share and Cite
Chinnapaiyan, M.; Selvam, Y.; Bassyouni, F.; Ramu, M.; Sakkaraiveeranan, C.; Samickannian, A.; Govindan, G.; Palaniswamy, M.; Ramamurthy, U.; Abdel-Rehim, M. Nanotechnology, Green Synthesis and Biological Activity Application of Zinc Oxide Nanoparticles Incorporated Argemone Mxicana Leaf Extract. Molecules 2022, 27, 1545. https://doi.org/10.3390/molecules27051545
Chinnapaiyan M, Selvam Y, Bassyouni F, Ramu M, Sakkaraiveeranan C, Samickannian A, Govindan G, Palaniswamy M, Ramamurthy U, Abdel-Rehim M. Nanotechnology, Green Synthesis and Biological Activity Application of Zinc Oxide Nanoparticles Incorporated Argemone Mxicana Leaf Extract. Molecules. 2022; 27(5):1545. https://doi.org/10.3390/molecules27051545
Chicago/Turabian StyleChinnapaiyan, Maheswari, Yashika Selvam, Fatma Bassyouni, Mathammal Ramu, Chandrasekar Sakkaraiveeranan, Aravindan Samickannian, Gobi Govindan, Matheswaran Palaniswamy, Uthrakumar Ramamurthy, and Mohamed Abdel-Rehim. 2022. "Nanotechnology, Green Synthesis and Biological Activity Application of Zinc Oxide Nanoparticles Incorporated Argemone Mxicana Leaf Extract" Molecules 27, no. 5: 1545. https://doi.org/10.3390/molecules27051545
APA StyleChinnapaiyan, M., Selvam, Y., Bassyouni, F., Ramu, M., Sakkaraiveeranan, C., Samickannian, A., Govindan, G., Palaniswamy, M., Ramamurthy, U., & Abdel-Rehim, M. (2022). Nanotechnology, Green Synthesis and Biological Activity Application of Zinc Oxide Nanoparticles Incorporated Argemone Mxicana Leaf Extract. Molecules, 27(5), 1545. https://doi.org/10.3390/molecules27051545

